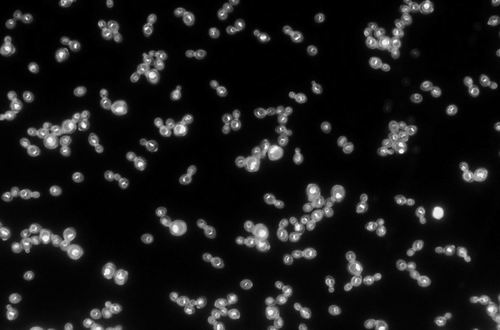

|
|
|
|
|
科学家创造出光动力酵母 |
|
有助研究进化、细胞衰老和生物燃料 |
改动基因后,酵母在光照下生长更快。图片来源:佐治亚理工学院
本报讯 酵母在发酵时需要黑暗的环境,暴露在光线下会阻碍甚至破坏这一过程。美国科学家在国际上首次设计出在光照下更“快乐”的光动力酵母菌株,其生长速度比在黑暗中快2%。相关研究成果近日发表于《当代生物学》。
光营养代谢指捕获光作为能量来源,这对生物界非常重要,能够增加生物圈的总能量。基于叶绿素的光合作用是最常见的光营养代谢,但植物并不是自然界唯一能将光转化为能量的生物。视网膜上的视紫红质传递的光能几乎与叶绿素一样多,且存在于更多的物种谱系中。
该研究的主要作者、美国佐治亚理工学院的Autumn Peterson说:“视紫红质遍布生命之树,显然是生物体在进化过程中从彼此获得的基因中得来的。”
这种类型的基因交换被称为水平基因转移,可在亲缘关系不密切的生物体之间共享遗传信息。水平基因转移可以在短时间内引发看似巨大的进化跳跃,比如细菌迅速对某些抗生素产生耐药性。
但是,视紫红质基因是如何进入具有复杂内膜结构的真核细胞的?
为了解答这一问题,研究团队选择酵母这种单细胞真核微生物进行了实验。他们将一种由寄生真菌合成的视紫红质基因插入普通酵母细胞的液泡中。结果,配备了视紫红质液泡的酵母,在光照下生长速度不仅没有减慢,反而提高了约2%。
“坦率地说,我们对将酵母转化为光生物的简单程度感到震惊。”该研究通讯作者、佐治亚理工学院的Anthony Burnetti表示。
这项研究的灵感来自该小组之前对多细胞生命进化的研究。去年,他们曾在《自然》发文,介绍了单细胞模式生物“雪花酵母”如何通过3000多代的进化,成为多细胞生物。在那项研究中,他们发现细胞进化的一个主要限制——能量。
Burnetti表示,由于氧气很难深入组织,后者无法获得足够的能量。而在不使用氧气的情况下,给生物体增加能量的另一种方法是通过光。从进化的角度来看,生物体将光转化为能量的分子机制要比利用氧气获得能量复杂得多,涉及大量很难在实验室和自然进化中获得的基因和蛋白质。
这项研究解释了为什么视紫红质能够在不同谱系的生物中广泛存在——它无须进化和优化,可以在没有额外细胞机制的情况下将光转化为能量,为生物体提供新的生物功能,使其获得进化优势。
由于液泡功能与细胞衰老有关,该小组还研究了加入视紫红质的酵母能否延缓衰老。此外,其他研究团队则在利用光动力酵母研究合成生物燃料。(陈欢欢)
相关论文信息:
https://doi.org/10.1016/j.cub.2023.12.044
《中国科学报》 (2024-01-24 第2版 国际)